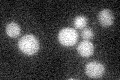
YGL150C
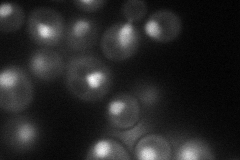
YGL150C
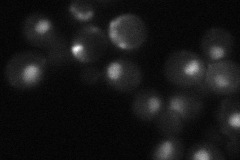
YGL150C
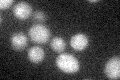
YGL150C
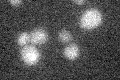
YGL150C

View description
ATPase, subunit of a complex containing actin and several actin-related proteins that has chromatin remodeling activity and 3' to 5' DNA helicase activity in vitro; has a role in modulating stress gene transcription
Localization:
Intensity:
Fold change:
Significance:
-
C’ GFP library in SD
below threshold16.18 -
N' NOP1pr-GFP in SD
punctate,nucleus69.7988 -
N' TEF2pr-mCherry in SD

nucleus6.73938 -
N' NATIVEpr-GFP in SD
nucleus38.4959 -
N' TEF2pr-VC and Cyto-VN in SD

#N/A0 -
C’ GFP library in SD+DTT
cytosol16.231No -
C’ GFP library in SD+H2O2

cytosol18.511.14No -
C’ GFP library in Starvation Media
cytosol16.180.99No -
C’ GFP library on the background of Pup2-DaMP

below threshold -
C’ GFP library on the background of CCT mutant

below threshold18.41721.13746No
